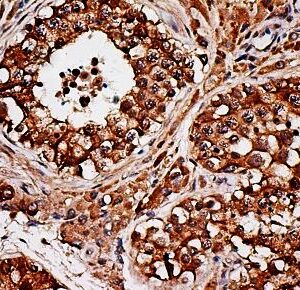
Anti-Inhibin, alpha (INHA), Clone INHA/4265

I
Showing 21–40 of 45 resultsSorted by latest
-

Anti-IL-6ST
Price range: $269.00 through $1,265.00 Select options This product has multiple variants. The options may be chosen on the product page -

Anti-IL-15
Price range: $269.00 through $1,289.00 Select options This product has multiple variants. The options may be chosen on the product page -

Anti-IL-3
Price range: $269.00 through $1,289.00 Select options This product has multiple variants. The options may be chosen on the product page -

Anti-IL-2
Price range: $269.00 through $1,289.00 Select options This product has multiple variants. The options may be chosen on the product page -

Anti-Interleukin-1beta
Price range: $269.00 through $1,215.00 Select options This product has multiple variants. The options may be chosen on the product page -

Anti-Interferon Alpha
Price range: $269.00 through $1,015.00 Select options This product has multiple variants. The options may be chosen on the product page -

Anti-IgD
Price range: $250.00 through $995.00 Select options This product has multiple variants. The options may be chosen on the product page -
![Anti-IgG [Polyclonal]](https://biogenex.seosmo.click/wp-content/uploads/2021/10/AR050GP-1-300x300.jpg)
Anti-IgG [Polyclonal]
Price range: $250.00 through $935.00 Select options This product has multiple variants. The options may be chosen on the product page -

Anti-INSM1(INSM1/6286R)
Price range: $269.00 through $979.00 Select options This product has multiple variants. The options may be chosen on the product page -

Anti-IgG4 [IGHG4/2042R]
Price range: $269.00 through $1,235.00 Select options This product has multiple variants. The options may be chosen on the product page -

Anti-Insulin
Price range: $389.00 through $995.00 Select options This product has multiple variants. The options may be chosen on the product page -

Anti-INI1/SNF5/SMARCB1
Price range: $269.00 through $1,079.00 Select options This product has multiple variants. The options may be chosen on the product page -

Anti- Interleukin 6, Clone 10C12
Price range: $269.00 through $1,495.00 Select options This product has multiple variants. The options may be chosen on the product page -
![Anti-INSM1 [A-8]](https://biogenex.seosmo.click/wp-content/uploads/2021/10/INSM1_AMB44_40X_2-300x300.jpg)
Anti-INSM1 [A-8]
Price range: $269.00 through $1,125.00 Select options This product has multiple variants. The options may be chosen on the product page -

Anti-IgG, Clone [RWP49]
Price range: $269.00 through $1,205.00 Select options This product has multiple variants. The options may be chosen on the product page -

Anti-INI-1, Clone A-5
Price range: $269.00 through $1,359.00 Select options This product has multiple variants. The options may be chosen on the product page -

Anti- IDH1, Clone IDH1/1152
Price range: $269.00 through $1,305.00 Select options This product has multiple variants. The options may be chosen on the product page -
Anti-Inhibin, alpha (INHA), Clone INHA/4265
Price range: $269.00 through $1,555.00 Select options This product has multiple variants. The options may be chosen on the product page -

Anti-IgA, Clone IA761
Price range: $269.00 through $975.00 Select options This product has multiple variants. The options may be chosen on the product page -

Anti-IDO
Price range: $250.00 through $675.00 Select options This product has multiple variants. The options may be chosen on the product page

